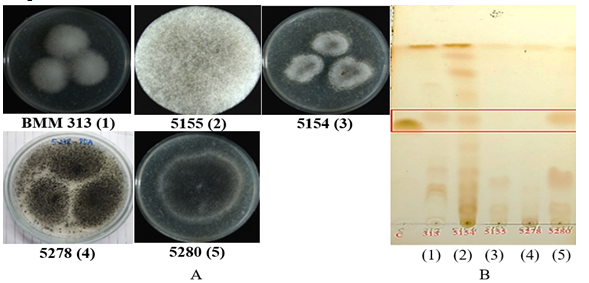

SÀNG LỌC CÁC CHỦNG VI NẤM Rhizopus sp. SINH TỔNG HỢP LOVASTATIN - CHẤT ỨC CHẾ ENZYM HYDROXYMETHYL GLUTARYL COENZYM A REDUCTASE- PHÂN LẬP Ở VIỆT NAM
Viện Công nghệ sinh học, Viện Hàn lâm Khoa học và Công nghệ Việt Nam, Học viện Khoa học và Công nghệ, Viện Hàn lâm Khoa học và Công nghệ Việt Nam
Số 18 Hoàng Quốc Việt, Cầu Giấy, Hà Nội
Số điện thoại: 02437568260; Email: dttuyen@ibt.ac.vn
Nội dung chính của bài viết
Tóm tắt (Abstract)
SCREENING OF LOVASTATIN PRODUCTION - AN HMG-CoA REDUCTASE INHIBITOR - BY Rhizopus sp. STRAINS ISOLATED IN VIETNAM
In this study, several Rhizopus sp. strains isolated from Vietnamese yeast bread samples were screened for their ability to produce lovastatin, an inhibitor of HMG-CoA reductase, using thin-layer chromatography (TLC). A solvent system of dichloromethane and ethyl acetate (70:30, v/v) revealed that two strains, Rhizopus sp. BMM 313 and Rhizopus sp. 5280, produced lovastatin. This conclusion was supported by the alignment of their TLC bands with a lovastatin standard (Sigma), exhibiting a retention factor (Rr) value of 0.57. Based on colony morphology and microscopic characteristics observed via scanning electron microscopy (SEM), Rhizopus sp. 5280 was reclassified as R. microsporus 5280. High-performance liquid chromatography (HPLC) analysis demonstrated that R. microsporus 5280 achieved the highest lovastatin yield at 34.59 mg/L. To optimize lovastatin production and investigate other secondary metabolites with HMG-CoA reductase inhibitory activity, this strain will be further studied to refine growth conditions and medium composition.
Từ khóa (Keywords)
HMG-CoA reductase, lovastatin, Rhizopus sp, R. Microsporus, secondary metabolites, chất chuyển hóa thứ cấp
Chi tiết bài viết
1. MỞ ĐẦU
Statin là những chất ức chế cạnh tranh với hydroxymethylglutaryl coenzym (HMG - CoA) reductase, làm ngăn cản chuyển HMG - CoA thành mevalonat, tiền chất của cholesterol. Các statin ức chế sinh tổng hợp cholesterol, làm giảm cholesterol trong tế bào gan, kích thích tổng hợp thụ thể LDL (lipoprotein tỷ trọng thấp) và qua đó làm tăng vận chuyển LDL từ máu. Kết quả cuối cùng của những quá trình hóa sinh này là giảm nồng độ cholesterol trong huyết tương. Ở liều bình thường, HMG - CoA reductase không bị ức chế hoàn toàn, do đó vẫn có đủ acid mevalonic cho nhiều quá trình chuyển hóa [1].
Các thuốc chống tǎng lipid máu bao gồm 5 nhóm chủ yếu: (1) Nhóm thuốc statin ngăn chặn tổng hợp cholesterol tại gan bằng cách ức chế cạnh tranh hoạt động của enzym HMG-CoA reductase, làm giảm tổng hợp cholesterol ở toàn bộ cơ thể; (2) thuốc gắn acid mật (resin) làm tăng gắn cholesterol với acid mật, do vậy thuốc làm tăng thải cholesterol qua đường mật; (3) thuốc ức chế ly giải lipid (nicotinic acid) làm giảm sự di chuyển acid béo tự do từ các tổ chức mỡ, do vậy gan sẽ có ít nguyên liệu để tổng hợp ra cholesterol; (4) nhóm thuốc fibrat làm tăng ly giải lipid ở ngoại biên và giảm sản xuất triglycerid ở gan; (5) thuốc ức chế hấp thu cholesterol (ezetimibe) có tác dụng ức chế hấp thu cholesterol một cách có chọn lọc ở ruột non. Mỗi nhóm có tác dụng hạ mỡ theo những cơ chế khác nhau [2]. Trong đó nhóm thuốc statin ngăn chặn tổng hợp cholesterol tại gan bằng cách ức chế cạnh tranh hoạt động của men HMG-CoA reductase, làm giảm tổng hợp cholesterol ở toàn bộ cơ thể. Statin là nhóm thuốc đã được chứng minh có hiệu quả tốt trong phòng ngừa bệnh lý tim mạch, kể cả bệnh mạch vành lẫn bệnh lý mạch máu não [3]. Vào năm 1987, Cục Quản lý Thuốc và Thực phẩm Mỹ (FDA) chấp thuận cho thuốc lovastatin (Mevacor) được bán ra ở Hoa Kỳ. Thuốc này được tạo ra từ nấm mốc. Lovastatin là một khám phá lớn trong lịch sử thuốc trị bệnh cholesterol cao, là thuốc đầu tiên thuộc nhóm thuốc statins hiện đang được sử dụng nhiều vì ít tác dụng phụ xấu mà lại có hiệu quả điều trị bệnh [4, 5].
Hiện nay có 5 dạng statin được sử dụng trong lâm sàng. Lovastatin và pravastatin (nguồn gốc từ mevastatin) là những statin tự nhiên có nguồn gốc từ nấm, trong khi đó symvastatin là một dẫn xuất lovastatin bán tổng hợp. Atorvastatin và fluvastatin là những statin tổng hợp từ mevalonat và pyridin. Ngoài ra đối với các statin tự nhiên chính, một số hợp chất tương tự như monacolin và dihydromonacolin được tách chiết từ các chất chuyển hóa trung gian từ nấm, cũng đã được đánh giá dược tính [1]. Các statin tự nhiên có thể nhận được từ các chủng giống nấm sợi khác nhau. Lovastatin được sinh tổng hợp chủ yếu bởi các chủng Aspergillus terreus (A. terreus), và mevastatin bởi Penicillium citrinum (P. citrinum). Pravastatin có thể nhận được bằng chuyển hóa sinh học từ mevastatin từ chủng Streptomyces carbophilus và simvastatin bằng một quá trình bán tổng hợp, có sự tham gia cải biến hóa học của chuỗi phụ lovastatin [1].
Lovastatin (C24H36O5) (mevinolin) có tên hóa học là axit butanoic 2-methyl-1,2,3,7,8,8a-hexahydro-3,7-dimethyl-8-[tetrahydro-4-hydroxy-6-oxo-2H-pyran-2-yl)-ethyl]-1-naphthalenyl este, [1S-(1a(R’), 31, 7b, 8b (2S’, 4S’), 8ab)]. Mevinolin là sản phẩm trao đổi chất bậc 2 của các chủng vi nấm có tác dụng giảm cholesterol máu, lần đầu tiên được tổng hợp và tách chiết từ Monascus ruber (M. ruber) theo phương pháp lên men chìm bởi Ando [6] (sản phẩm mevinolin hay monacolin K từ Monascus) và từ A. terreus (lovastatin). Từ đó đến nay, rất nhiều chủng vi nấm thuộc các chi Aspergillus (A. terreus, A. flavipes,…), Monascus (M. ruber, M. purpureus, M. pilosus, M. anka,…), Penicilium (P. citrinum, M. patulum,…) được công bố là có khả năng tổng hợp lovastatin và các đồng phân tương tự. Chủng A. terreus ATCC 20542 được lưu giữ trong Sưu tập giống của Mỹ đã được lựa chọn để sản xuất lovastatin ở quy mô công nghiệp theo phương pháp lên men chìm. Phương pháp lên men bề mặt và phương pháp kết hợp giữa nuôi cấy bề mặt và nuôi cấy chìm M. ruber để sản xuất monacolin K đã được Chang và cộng sự mô tả năm 2002 [4].
Seydametova và cộng sự đã khảo sát 54 chủng nấm và sàng lọc được 4 chủng Penicillium có khả năng sinh tổng hợp các hợp chất statin. Statin trong dịch lên men nấm đã được chiết với ethyl acetat và được xác định bằng phương pháp sắc ký lỏng cao áp HPLC. Chủng Penicillium sp. ESF2M có khả năng sinh tổng hợp lovastatin mạnh nhất, với năng suất đạt 20 mg/L [7]. Hai chủng nấm P. citrinum và Trichoderma viride (T. viride) có khả năng sinh tổng hợp các hoạt chất trong nhóm statin như lovastatin tương ứng đạt năng suất 61 và 4,1 mg/L. Các loại nấm sau đây cũng đã được công nhận có khả năng sản xuất lovastatin như A. terreus (55 mg/L), Penicillium funiculosum (pinophilum) (19,3 mg/L) và nấm T. viride (9 mg/L) [8]. Reddy và cộng sự đã nghiên cứu khả năng sản xuất lovastatin từ chủng P. funiculosum NCIM 1174. Chủng này được lên men rắn trong môi trường là các phế phụ phẩm công nghiệp như trấu, vỏ trấu đen, cám lúa mì và vỏ cam. Kết quả là cám lúa mì được phát hiện là cơ chất phù hợp nhất với năng suất lovastatin đạt 5,3 mg/g cơ chất khô [5]. Chủng Rhizopus oryzae (R. oryzae) có khả năng sinh tổng hợp lovastatin đạt 20,39 mg/L (HPLC) được phát hiện vào năm 2019 [9].
Ở Việt Nam, nghiên cứu khả năng sinh tổng hợp lovastatin từ các chủng Rhizopus sp. còn chưa được công bố. Đã có một số nghiên cứu phân lập chủng Monascus sp. sinh tổng hợp lovastatin [1, 10], nâng cao khả năng sinh tổng hợp lovastatin từ chủng A. terreus bằng công nghệ lên men [11, 12] hay bằng kỹ thuật đột biến [13]. Mục tiêu chính của nghiên cứu này là sàng lọc các chủng nấm Rhizopus sp. có khả năng sinh tổng hợp lovastatin cao. Trên cơ sở đó tiếp tục nghiên cứu nâng cao năng suất sinh tổng hợp lovastatin và tinh sạch hoạt chất lovastatin từ chủng Rhizopus sp. đã được tuyển chọn.
2. VẬT LIỆU VÀ PHƯƠNG PHÁP NGHIÊN CỨU
2.1. Chủng giống
Bộ chủng vi nấm bao gồm chủng Rhizopus sp. 5155, Rhizopus sp. 5154, Rhizopus sp. BMM 313, Rhizopus sp. 5280 và Rhizopus sp. 5278 phân lập từ các bánh men được cung cấp từ Bộ chủng của Viện Công nghệ thực phẩm - Bộ Công thương. Các chủng vi nấm được ria cấy lên trên đĩa thạch PDA và nuôi lên men trong môi trường PDB ở 30°C, thời gian 14 ngày.
2.2. Hóa chất và môi trường
Các hoá chất sử dụng trong thí nghiệm đều ở dạng tinh khiết, được mua từ các hãng hoá chất có uy tín: methanol (Xilong Scientific) độ tinh khiết ≥ 99.5%, ethyl acetat (Xilong Scientific) độ tinh khiết ≥ 99.5%, dichloromethan (Xilong Scientific) độ tinh khiết ≥ 99.5%, D-glucose (Bio basic Canada INC.) độ tinh khiết ≥ 99.5%, lovastatin (Sigma) độ tinh khiết 99%.
Môi trường potato dextrose broth (PDB): 20% dịch chiết khoai tây, 2% dextrose.
Môi trường potato dextrose agar (PDA): 20% dịch chiết khoai tây, 2% dextrose, 2% agar.
2.3. Phân loại chủng bằng đặc điểm hình thái
Các chủng nấm sử dụng trong nghiên cứu mới được định danh đến chi. Vì vậy, trong nghiên cứu này, đặc điểm sinh học bao gồm hình dạng khuẩn lạc nấm, đặc điểm cơ quan sinh sản và bào tử phân sinh được xác định để định danh loài nấm. Hình thái nấm được xác định sử dụng kính hiển vi điện tử quét phát xạ trường FE-SEM (Field Emission Scanning Electron Microscope- FE-SEM, Hitachi-S4800, Nhật Bản).
2.4. Lên men chủng nấm Rhizopus sp.
Chủng Rhizopus sp. được hoạt hóa trong môi trường PDB (potato dextrose broth) ở nhiệt độ 28 - 30°C, lắc 200 rpm. Sau 24 - 48 h, nuôi chủng trên đĩa thạch PDA ở nhiệt độ phòng trong 5 - 7 ngày. Sau đó, chủng Rhizopus sp. được lên men trong môi trường PDB, lắc 200 vòng/min ở nhiệt độ 28 - 30°C trong 7 ngày [9, 14]. Sau 7 ngày thu dịch ngoại bào, ly tâm 10000 vòng/min trong 10 min, ở 4°C để loại bỏ sinh khối tế bào. Dịch sau ly tâm được định tính bằng sắc ký lớp mỏng (TLC) và xác định hàm lượng lovastatin bằng sắc ký lỏng hiệu năng cao (HPLC).
2.5. Phương pháp tách chiết các hoạt chất từ các chủng Rhizopus sp.
Dịch nuôi cấy sau 7 ngày lên men được chiết qua màng lọc thu dịch trong, đưa lên cột than hoạt tính để loại màu, hạ pH xuống 3,0 bằng HCl 1N và chiết với ethyl acetat (tỷ lệ 1:1) trong 2 giờ. Sau đó thu pha dung môi và cô đặc bằng thiết bị cô quay chân không Buchi.
Sắc ký lớp mỏng được thực hiện trên bản mỏng silica gel Merck 60 F254, dày 0,25mm, sau đó hiện màu bằng thuốc thử iot. Sản phẩm cao chiết có chứa lovastatin được kiểm tra bằng phương pháp sắc ký lớp mỏng với hệ dung môi dichloromethan: ethylaxetat = (7:3) trên bản sắc ký bản mỏng. Lovastatin (Sigma) được sử dụng làm chất chuẩn.
2.6. Xác định hàm lượng lovastatin bằng sắc ký lỏng hiệu năng cao (HPLC)
Dịch nuôi cấy sau khi lọc qua giấy lọc, chỉnh pH về 3 bằng HCl 1 N, tiến hành chiết lovastatin trong dịch lọc bằng ethyl acetat theo tỉ lệ 1:1 (v/v). Dịch chiết có chứa lovastatin sau khi cô quay sẽ được hòa tan trong 200 µl hỗn hợp acetonitril: H3PO4 0,1% (60: 40, v/v). Hỗn hợp sau đó được ly tâm 13.000 vòng/phút và sử dụng 5 µl nổi để phân tích HPLC với cột C18, pha động acetonitril: H3PO4 0,1% (60:40). Tín hiệu được ghi nhận bằng detector UV ở bước sóng 238 nm [8].
Xây dựng đường chuẩn:Vẽ đồ thị biểu diễn mối quan hệ giữa diện tích peak (trục Y) và nồng độ lovastatin (trục X). Xác định phương trình đường chuẩn và hệ số tương quan (R²).
Kiểm tra và xác nhận: Tiêm lại các dung dịch chuẩn nhiều lần (ít nhất 3 lần) để kiểm tra độ lặp lại của diện tích peak. Phân tích mẫu kiểm chuẩn với nồng độ đã biết và so sánh kết quả thu được với giá trị thực tế để xác nhận độ đúng và độ chính xác của phương pháp.
2.7.Xử lý số liệu
Các số liệu được xử lý bằng phần mềm MS Excel 2016. Các giá trị được biểu diễn dưới dạng
(
là giá trị trung bình, SD là độ lệch chuẩn).
3. KẾT QUẢ VÀ THẢO LUẬN
3.1. Tuyển chọn chủng nấm Rhizopus sp. có khả năng sinh tổng hợp lovastatin
05 chủng nấm Rhizopus sp. được hoạt hóa trong môi trường PDA và lên men trong môi trường PDB pH 5,5- 6, lắc ở vận tốc 200 vòng/min, thời gian lên men là 14 ngày. Các chủng nấm Rhizopus sp. sau khi được lên men sẽ được tiến hành tách chiết sơ bộ theo phương pháp đã mô tả ở trên, sử dụng phương pháp sắc ký lớp mỏng với chất chuẩn là lovastatin.
![]() |
Hình 1. Hình ảnh khuẩn lạc (A) và sắc ký lớp mỏng (B) của các mẫu dịch chiết ethyl acetat có chứa lovastatin - hoạt chất ức chế enzym HMG-CoA reductase- từ các chủng Rhizopus sp.. (1-5: mẫu dịch chiết ethyl acetat tương ứng của các chủng Rhizopus sp. (1), Rhizopus sp.(2), Rhizopus sp.(3), Rhizopus sp (4). và Rhizopus sp. (5) |
Kết quả thu được cho thấy ở các làn số 1, 2 và 5 tương ứng với 03 chủng Rhizopus sp. BMM (1), Rhizopus sp. (2), Rhizopus sp. (5) có xuất hiện một băng đậm với Rf= 0,57 gần ngang với chất chuẩn lovastatin (làn C) (Hình 1). Trong đó mẫu làn số 5 xuất hiện băng ở vị trí gần với chất chuẩn đậm nét nhất so với hai mẫu còn lại, mẫu số 2 lại xuất hiện rất nhiều băng có các Rf khác nhau, mẫu làn số 1 là xuất hiện ít băng phụ nhất. Hai mẫu làn số 3 và số 4, tương ứng với 2 chủng Rhizopus sp. 5155, Rhizopus sp. 5154 không thấy xuất hiện băng ngang chuẩn. Như vậy là chúng tôi đã chọn được 02 chủng Rhizopus sp. có mã số BMM 313 và 5280 có khả năng sinh tổng hợp lovastatin, trong đó chủng Rhizopus sp. 5280 có khả năng sinh tổng hợp lovastatin tốt nhất.
Các chủng có khả năng sinh tổng hợp lovastatin sẽ tiếp tục được nuôi trên đĩa môi trường PDA để tiến hành quan sát hình thái các khuẩn lạc và các đặc điểm vi thể (SEM) trên kính hiển vi điện tử (Hình 2).
![]() Chủng Rhizopus sp. BMM 313 |
![]() Chủng Rhizopus sp. 5280 Hình 2. Hình thái khuẩn lạc trên môi trường PDA chuẩn (A) và sợi nấm (B) của hai chủng Rhizopus sp. (1) và Rhizopus sp. (5) trên kính hiển vi quang học 1000x |
Hầu hết các chủng nấm phân lập đều có khuẩn lạc phát triển, chúng nhanh chóng chuyển từ màu trắng sang tối khi tạo ra các bào tử và có kết cấu tương tự như kẹo bông trên môi trường Czapek [7]. Qua phân tích đặc điểm của khuẩn lạc và vi thể của 02 chủng Rhizopus sp. BMM 313 và Rhizopus sp. 5280, chúng tôi nhận thấy 02 chủng này có đặc điểm của loài R. oryzae và Rhizopus microsporus (R. microsporus) như Sợi nấm: R. microsporus bao gồm các sợi nấm dài, phân nhánh và có vách ngăn hoặc vách ngăn phân chia sợi nấm thành các ô riêng lẻ. Túi bào tử: Túi bào tử là những cấu trúc giống như túi được gắn vào các đầu của sợi nấm trên không, có dạng hình cầu hoặc hình elip và có lớp vỏ ngoài màu sẫm. Túi bào tử chứa nhiều bào tử. Túi bào tử thường mọc thẳng và có thể phân nhánh để tạo ra nhiều túi bào tử. Bào tử vô tính gọi là túi bào tử, bào tử có màu tối và xuất hiện dưới dạng khối bột. Bào tử được giải phóng khỏi túi bào tử và có thể phân tán trong không khí. Nghiên cứu về đặc điểm khuẩn lạc và đặc điểm vi thể đều cho các đặc điểm phù hợp với chủng nấm R. microsporus [8].

Hình 3. Đặc điểm vi thể của chủng R. microsporus 5280 trên môi trường PDA (A): Sợi nấm chủng R. microsporus5280 trên kính hiển vi quang học 1000 x; (B): Hình ảnh SEM của chủng R. microsporus 5280
3.2. Định lượng lovastatin bằng HPLC
Chủng R.s microsporus 5280 được nuôi cấy trên máy lắc ở 30°C trong 14 ngày trên môi trường lên men. Lovastatin được tách chiết bằng ethyl acetat từ môi trường lên men đã axit hóa, cô đặc bằng cất quay chân không, lọc qua màng lọc 0,45 µm và được phân tích định lượng bằng phương pháp HPLC. Kết quả cho thấy chủng R. microsporus 5280 tổng hợp lovastatin đạt 34,59 mg/L (Hình 4).
Phân tích sắc ký lỏng hiệu năng cao cho thấy mẫu chuẩn lovastatin xuất hiện duy nhất một peak có thời gian lưu (RT) ở 1,783 phút (Hình 4B). Trong khi đó mẫu dịch chiết ethyl acetat từ chủng R. microsporus 5280 xuất hiện 4 peak với các thời gian lưu khác nhau tương ứng là 1,267 phút, 1,371 phút, 1,540 phút và 1,763 phút, trong đó có một peak có thời gian lưu được chấp nhận trùng với mẫu chuẩn lovastatin là 1,763 phút (chênh lệch ≈ 1,1% giá trị thời gian lưu) (Hình 4C).
![]() |
A |
![]() |
B |
![]() |
C |
Hình 4. Sắc đồ HPLC của lovastatin từ mẫu dịch chiết chủng nấm R. microsporus 5280 (A): Đường chuẩn có sử dụng lovastatin (Sigma); (B) sắc ký đồ chuẩn lovastatin; (C) mẫu dịch chiết ethyl acetat chứa lovastatin của chủng R. microsporus 5280 |
Dựa trên đường chuẩn Hình 4A thu được với Y=1.102 X+29.342 cho thấy hàm lượng lovastatin trong mẫu dịch chiết ethyl acetate từ chủng R. microsporus 5280 được xác định là 34,59 mg/L. Theo nghiên cứu của Immanuel và Anusha, khả năng sinh tổng hợp lovastatin từ chủng R. oryzae phân lập từ đất (xác định bằng trình tự gene 18S rDNA), cho thấy ở mẫu dịch chiết bằng ethyl acetat, hàm lượng lovastatin đạt 20,39 mg/L (HPLC) [9]. Các chủng nấm A. terreus trong nghiên cứu có khả năng tổng hợp lovastatin cao nhất đạt 55 mg/L [12] và đạt 194-289 mg/L ở nghiên cứu [15]. Seydametova và cộng sự nghiên cứu khả năng sinh tổng hợp một chất ức chế HMG- CoA reductase (pravastatin) được sinh tổng hợp từ chủng Penicillium janthinellum phân lập từ mẫu đất cho thấy hàm lượng đạt 15,8 mg/lít khi được xác định bằng sắc ký HPLC [16].
Trong nghiên cứu này hàm lượng lovastatin từ chủng R. microsporus 5280 đạt 34,59 mg/L là cao hơn so với một số nghiên cứu trên thế giới chỉ đạt từ 15,8- 55 mg/L [7, 17] và thấp hơn nghiên cứu đạt 194-289 mg/L [15].
4. KẾT LUẬN
Từ các số liệu thu được cho thấy trong số 04 chủng Rhizopus sp. phân lập từ bánh men đã tuyển chọn được 02 chủng có khả năng sinh tổng hợp lovastatin (được kiểm tra bằng phương pháp sắc ký lớp mỏng sử dụng hệ dung môi dichlomethan: ethyl acetat với tỉ lệ 70:30 (v/v) xuất hiện băng ngang chuẩn lovastatin (Sigma) với hệ số Rf = 0,57). Trong đó 01 chủng Rhizopus sp. 5280 có khả năng sinh lovastatin cao nhất đã được định danh tương ứng là chủng R. microsporus 5280 theo phương pháp định danh dựa vào đặc điểm khuẩn lạc và vi thể. Năng suất tổng hợp lovastatin của chủng R. microsporus 5280 đạt 34,59 mg/L. Các kết quả nghiên cứu này sẽ là cơ sở cho các nghiên cứu tiếp theo về tách chiết tinh sạch và thu nhận hoạt chất ức chế enzym HMG CoA- reductase từ các chủng nấm Rhizopus sp. phân lập ở Việt Nam.
Lời cảm ơn: Công trình có sự hỗ trợ kinh phí của đề tài cấp Viện Hàn lâm KH&CN Việt Nam "Sàng lọc, chiết xuất, tinh sạch và xác định cấu trúc của một số hợp chất thứ cấp định hướng ứng dụng trong điều trị bệnh mỡ máu từ chủng nấm phân lập ở Việt Nam”, mã số: KHCBSS.01/23-25, 2023-2025.
Tài liệu tham khảo
2. Tobert, O.A., Lovastatin and beyond the history of the HMG-CoA reductase inhibitors, Nature reviews drug discovery, 2003, 2(7):517-526. DOI:10.1038/nrd1112
3. Di Napoli, M., Benefit of statins in cerebrovascular disease, Current opinion in investigational drugs, 2004, 5(3):295-305.
4. Chang, Y., et al., Use of response surface methodology to optimize culture medium for production of lovastatin by Monascus rubber, Enzyme Microb Technol, 2002, 30:889-894. DOI:10.1016/S0141-0229(02)00037-6
5. Reddy, S.R., P. Latha, and H. Latha, Production of lovastatin by solid state fermentation by Penicillium Funiculosum NCIM 1174, Drug Invention Today, 2011, 3(6):75-77.
6. Endo, A., Monacolin K, a new hypocholesterolemic agent produced by a Monascus species, The Journal of Antibiotics, 1979, 32(8):852-854. DOI:10.7164/antibiotics.32.852
7. Seydametova, E., et al., Production of lovastatin by Penicillium spp. soil microfungi, International Journal of Chemical Engineering and Applications, 2012, 3(5):337-339. DOI:10.7763/IJCEA.2012.V3.213
8. Lê Đức Mạnh, Khảo sát khả năng tạo sắc tố lovastatin và độc tố citrinin của hai chủng nấm mốc đỏ Monascus purpureus, Tạp chí Khoa học ĐHQGHN, Khoa học Tự nhiên và Công nghệ, 2007, 23:238-244.
9. Immanuel, S. and P.J.A.S.M.S. Anusha, Production of lovastatin by soil microfungi Rhizopus oryzae, 2019, 3(1):70-74.
10. Đỗ Thị Tuyên, et al., Tạo các dòng đột biến Asperillus terreus để nâng cao tổng hợp lovastatin. Tạp chí Khoa học và công nghệ 2012. 50(3B):105- 112.
11. Nguyễn Lân Dũng, Nguyễn Đình Quyến, Phạm Văn Ty, Vi sinh vật học, NXB Giáo Dục, 1997.
12. Samiee, Siamak M., et al., Screening of lovastatin production by filamentous fungi. Iranian Biomedical Journal 2003, 7(1):29-33.
13. Wei, P.l., Z.N. Xu, and P.l. Cen, Lovastatin production by Aspergillus terreus in solid-state fermentation, J. Zhejiang University - Science A, 2007, 8:1521-1526. https://doi.org/10.1631/jzus.2007.A1521
14. Samiee, S.M., et al., Screening of lovastatin production by filamentous fungi, Iran Biomed J., 2003, 7(1):29-33.
15. Sree, D.K., et al., Isolation and screening of lovastatin producing Aspergillus terreus fungal strains from soil samples, International Journal of Pharmacy & Techonology, 2011, 3(2):2772-2782
16. Seydametova, E. Novel pravastatin-producing Penicillium janthinellum strain isolated from soil. Int. J. Biosci. Biochem. Bioinform, 2015, 5(2): 80-90. doi: 10.17706/ijbbb.2015.5.2.80-90
17. Phạm Đức Toàn, Đ.T.T.H., Bùi Thị Hồng Phương, Đỗ Thị Thủy Lê, Nguyễn Thị Hoài Trâm, Nghiên cứu sàng lọc, lựa chọn và nâng cao hiệu suất tổng hợp lovastatin từ các chủng Aspergillus terreus, Tạp chí Khoa học và Công nghệ 2012, 3C(50):553-562.